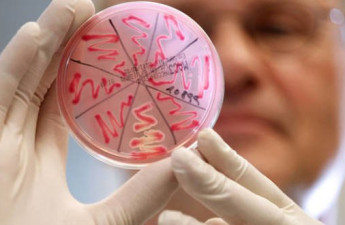

Відключення електроенергії у Луцьку й на Волині 18 жовтня
ПАТ «Волиньобленерго» інформує мешканців Луцька й Волинської області про відключення споживачів від електромережі у вівторок, 18 жовтня
17 Жовтня 2016 17:21
Перехрестя-«озеро» у Луцьку: чиновники запевняють, що мають план дій
Після першого серйозного дощу перетин вулиць Кравчука та Воїнів-інтернаціоналістів перетворюється на водойму. Пішоходи обходять, а водії об’їжджають його десятою дорогою. Скаржаться, що попри численні звернення, міська влада проблему не вирішує
17 Жовтня 2016 17:05

Зухвалий злочин: волинські поліцейські затримали учасників розбійного нападу

Двох злочинців, один з яких перебуває у міжнародному розшуку, волинським поліцейським вдалося знати та затримати у Житомирі після зухвалого розбійного нападу зловмисників на ювелірний магазин у Володимирі-Волинському
17 Жовтня 2016 16:47

У Луцьку цілу ніч дивитимуться фільми Білла Мюррея
«Lutsk Night Cinema» кличе лучан на ніч із Біллом Мюрреєм
17 Жовтня 2016 16:38

Завтра у Луцьку на декількох вулицях відключать воду
КП “Луцькводоканал” повідомляє про відключення води 18 жовтня
17 Жовтня 2016 16:22

На Волині лісівники виростили понад сотню диких качок
Розведенням диких качок займаються лісівники Шацького лісництва
17 Жовтня 2016 16:14

На трасі «Ковель-Ягодин» вантажівка насмерть збила людину
На автодорозі сполученням «Київ-Ковель-Ягодин» водій вантажівки здійснив наїзд на пішохода. Внаслідок ДТП, пішохід помер на місці події
17 Жовтня 2016 15:59

У Ківерцях три дні ремонтуватимуть залізничний переїзд
Із 17 по 19 жовтня у Ківерцях на вулиці Луцькій будуть здійснюватись ремонтні роботи
17 Жовтня 2016 15:47

У ДТП на Волині загинула людина
У дорожньо-транспортній пригоді загинув молодий хлопець
17 Жовтня 2016 15:15

Mercedes із деревиною без документів затримали на Волині
Автомобіль, який перевозив деревину без документів, затримали у Маневицькому районі
17 Жовтня 2016 15:01

На Волині молоді патріоти змагалися на терені. Фото
Теренова гра "Булава" для молоді за підтримки Маневицької Районної Організації Ветеранів АТО та "Національного Альянсу" вперше відбулася у Маневичах 16 жовтня
17 Жовтня 2016 14:44
.jpg)
У Луцьку 93 випускники поліцейської академії отримали дипломи
У Волинському відділенні Національної академії внутрішніх справ випускникам вручили дипломи
17 Жовтня 2016 14:29

В ОДА – за реорганізацію дільничних лікарень на Волині

Непопулярним, але ефективним кроком вважають в облдержадміністрації закриття трьох дільничних лікарень у Старовижівському районі та створення на їхній базі пунктів екстреної медичної допомоги
17 Жовтня 2016 14:18
.jpg)
У Луцьку під час концерту Єгора Грушина покажуть магічне візуальне шоу
У рамках всеукраїнського туру піаніст та композитор Єгор Грушин відвідає Луцьк. Вже 18 жовтня о 19:00 в Палаці кульутри (вулиця Богдана Хмельницького, 1) відбудеться унікальний, атмосферний концерт музики у стилі modern classical
17 Жовтня 2016 14:03

Аеропорти України повністю позбудуться російської мови
До 1 грудня аеропорти України мають перейти на роботу тільки українською чи англійською мовою та позбутися комуністичних назв
17 Жовтня 2016 13:49

Волинські прикордонники виявили 8 ящиків цигарок, захованих у човні
Прикордонники відділу «Новогрузьке» Луцького загону викрили чергову оборудку жителів прикордоння з незаконного переміщення цигарок через Західний Буг за допомогою гумового човна
17 Жовтня 2016 13:33
На Волині підвищується рівень інфекційних захворювань

Значне підвищення рівня поширення інфекційних захворювань на низькі показники вакцинації: епідеміологічну ситуацію в області проаналізувала директор обласного лабораторного центру
17 Жовтня 2016 13:18

На Кічкарівці горіла господарська споруда
Пожежа в господарській споруді на вулиці Добролюбова, 1 сталася у Луцьку 15 жовтня
17 Жовтня 2016 12:58
Сьогодні 12:24
Сьогодні 11:28
Сьогодні 11:00
Сьогодні 10:32
Сьогодні 09:36
Сьогодні 09:08
Сьогодні 07:43















.jpg)













